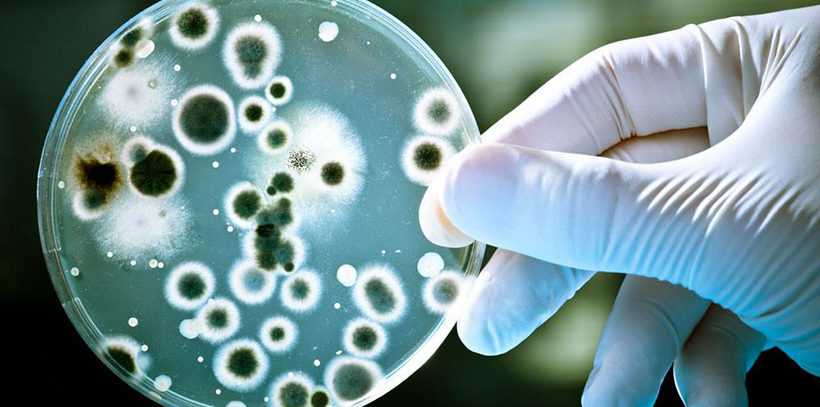

生命科學和生物工程技術的迅速發展使得人們對核苷酸、核酸、以及氨基酸、多肽、蛋白質等生物分子的研究興趣日益增加。這些生物活性分子是人類生命延續過程所必需攝取的成分,因此涉及它們的分離、分析問題也日益重要。

高效液相色譜法(HPLC)是20世紀60年代末發展起來的一種分離分析新技術,適用于分析高浮點不易揮發的、受熱不穩定的和分子量大的有機化合物,并具有分離效率高、靈敏度高和分析速度快等優點。高效液相色譜法中的反相色譜法、體積排阻色譜法、親和色譜色譜法、離子色譜法等均可以對上述生物分子進行分離分析。

隨著分子生物學的不斷發展及各種新技術的廣泛應用,細菌的分類鑒定已從傳統的表型特征描述深入到各種細菌細胞成分的化學分析和分子生物學鑒定。通過化學測定,可以獲得細菌基因組和各細菌組分的化學數據,依據這些化學成分數據可以在對細菌做出精確鑒定,對許多菌株之間的親緣關系做出判斷。
每一種細菌DNA G+C 含量通常是恒定的,不受菌齡、生長條件等各種外界因素的影響,故它作為鑒定細菌種、屬間的親疏關系的重要指標已被人們所公認。測定DNA G+C 含量的方法已有眾多研究報道,主要包括熱變性溫度(Tm)法、浮力密度法和HPLC 法,其中快速、準確的方法當數HPLC法。
HPLC應用于細菌的分子生物學鑒定和細菌細胞的化學成分分析可直接測定細菌DNA的堿基組成和細菌的化學組分,為細菌的分類鑒定提供有利的證據。因此,HPLC 在微生物鑒定中的應用越來越受到人們的關注。

隨著氨基酸的廣泛應用,對氨基酸的檢測分析水平也在不斷提高。由于HPLC技術無需特殊反應裝置,高效、簡便、快速、準確和價格低廉等優點,已廣泛應用于多種生物樣品內氨基酸的檢測。
實驗所用色譜柱常采用C18柱、C8柱以及CN柱,檢測器使用紫外、熒光或電化學。氨基酸與不同生化試劑反應后產生不同的衍生物,不同衍生物所需色譜條件也有差別。HPLC已成為一種較為理想的檢測氨基酸的方法。

生物活性肽以其特有的吸收機制、極強的活性和多樣性成為國內外研究的熱點,其分離與分析技術是生物技術實現產業化的重中之重。化學合成的肽產品是一個純度不好的粗產品,其雜質與合成的肽在分子結構和化學性質上很相似,給肽的分離純化帶來了困難。因此,根據對目的肽的要求,需要選擇適當的方法進行純化。
高效液相色譜法是生物技術中分離純化的重要方法,在多肽的分離純化工藝中顯示出優異的性能。而且,它已走出實驗室投入到大規模的工業化生產中,成為生物技術范圍內一有力高效的分離工具。

作為生物大分子的蛋白質,是一種長鏈高分子化合物,不僅分子量大,而且在溶液中的擴散系數小、黏度大、易受外界溫度、酸度、有機溶劑的影響而并引起結構變化。這增加了蛋白質分離、分析的困難。
蛋白質在物理、化學及功能上的差異為蛋白質的分離檢測提供了基礎。用高效液相色譜法來分析蛋白質是一種近年來發展較快的新型分析方法。由于高效液相色譜柱的改進和HPLC技術的迅速發展,HPLC在蛋白質分析研究中越趨成熟。

隨著現代科學技術的日益發展,生物技術尤其是近年來基因科學技術的突飛猛進,已使醫藥工業產生了巨大的變化。生物技術不僅提供著基因工程多肽藥物和疫苗、診斷治療用單克隆抗體等日益豐富的生物工業藥物,并直接形成了初具規模的生物技術制藥產業;而且還在新藥篩選、改進現有藥物的生產工藝,改良微生物藥物的生產菌種、藥物的手性合成技術等方面愈益發揮作用。

生物技術必須實現產業化才能取得應有的社會和經濟效益,根據國際發展生物技術的經驗和資料可知在醫藥領域中,下游技術在生物技術產品中所占比例極大,可以說,下游技術是新藥高科技實現產業化的關鍵。而在制藥工程的下游技術中,產品的分離純化是其中最主要的組成部分。而高效液相色譜儀在生命科學和生物工程技術中的應用對建立一套完整的生物分子分離純化技術具有重要意義。
